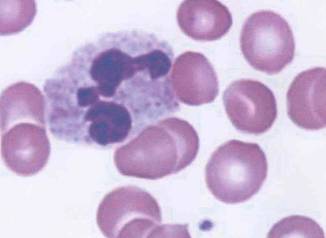
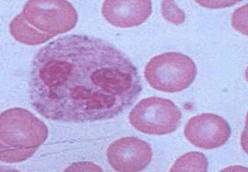

| CATEGORII DOCUMENTE |
| Alimentatie nutritie | Asistenta sociala | Cosmetica frumusete | Logopedie | Retete culinare | Sport |
ABERATII
CROMOZOMIALE ASOCIATE CU TULBURARI ALE DIFERENTIERII SEXUALE SI INFERTILITATE
LA
INTRODUCERE
Lucrarea de fata si-a propus sa imbine metodele citogeneticii clasice cu cele moleculare in scopul studierii disfunctiilor sexuale la om.
Daca in faza initiala a cercetarii, m-am axat pe aplicarea tehnicilor de bandare clasice, in special bandarea G, teste ELIZA, test Barr, pentru cea de a doua etapa, m-am concentrat pe tehnicile de citogenetica moleculara, in special pe tehnica FISH, si aplicabilitatea lor in domeniul geneticii umane. Tehnica FISH ( Fluorescence in situ hybridization) este una din cele mai utilizate in laboratoarele de diagnostic citogenetic, permitand evidentierea anomaliilor cromozomale, atat numerice cat si structurale, chiar si in nucleii interfazici. Avantajele majore pe care le ofera sunt: relativa simplitate a tehnicii, faptul ca poata fi folosita pe preparate deja arhivate, timpul de procesare si analiza destul de scurt si nu altereaza morfologia celulelor.
Materiale si metode
Am luat in studiu un lot de aproximativ 200 persoane de ambele sexe, avand o simtomatologie larga in materie de disfunctii sexuale, de la forme usoare pana la forme destul de grave care afectau capacitatea de reproducere.
1. Obtinerea de culturi de limfocite prin metoda standard, la care in scopul optimizarii culturilor am lucrat pe culturi pure, prin sapararea limfocitelor pe ficoll, si verificarea puritatii prin preparate microscopice
2. Aplicarea testului Barr pe frotiuri obtinute din singe periferic, colorate May-Grunwald-Giemsa
3. Aplicarea testului ELIZA pentru dozajul hormonal
4. Aplicarea tehnicii de bandare Giemsa, in vederea realizarii cariotipurilor.
5. Prelucrarea computerizata a imaginilor microscopice prin programul Image Pro si realizarea cariotipurilor.
6. Aplicarea tehnicii FISH pe preparatele selectate: lamele au fost pretratate cu RNA- aza 30- 60 minute la 37 grade Celsius, spalate su 2xSSC 5 minute cu agitare, tratate cu PBS/50mM MgCl2 5 minute si deshidratate intr-o serie de etanol 70%, 90%, 100% cate un minut fiecare.Sondele au suferit un tratament de prehibridare dupa cum urmeaza :mixul de hibridare(2 l DNA marcat cu biotina+1l Cot 1 DNA+ 7 l MM2.1) a fost deneturat la 75 grade Celsius 5-7 minute urmat de o tratare la gheata de 3 -5 minute si o incubare la 37 grade Celsius intre 15 minute si 2 ore. Urmatorul pas a fost denaturarea metafazelor, care s-a realizat la 75 grade celsius timp de 2 minute pe o baie de apa, urmata de mai multa spalari cu 2xSSC rece si o deshidratare cu etanol rece 70%, 90%, 100% cate un minut fiecare
Pentru hibridizare se aplica 10 l de mix pe lame, se acopera imediat si se lasa la 37 grade Celsius peste noapte. Dupa hibridizare urmeaza o serie de spalari, marirea semnalului cu avidina FITC si vizualizarea preparatelor.
Rezultate si discutii
Din lotul de 200 indivizi luati in discutie, majoritatea (90%) prezentau dezechilibre hormonale detectate prin metode ELISA (am avut in vedere valorile steroizilor si gonadotropilor hipofizari), dar doar la un mic procentaj 3% dintre pacienti am intalnit, asociate, anomalii cromozomiale atat numerice cat si structurale, si anume :
doua cazuri de sindrom Klinefelter,
un caz de sindrom XXX
patru cazuri de sindrom Turner, dintre care unul clasic si trei cu anomali structurale pe cromozomul X.
Tehnica FISH a fost adaptata pentru a putea vizualiza preparatele la microscopul cu fluorescenta din dotarea laboratorului nostru. Am preferat marcarea cu biotina si detectarea cu avidina FITC (verde) respectiv digoxigenina si detectata cu antidigoxigenin rodamina ( rosu).
CONCLUZII
1. Aplicarea testului Barr si a testelor ELIZA permit selectarea initiala si diagnosticarea pacientilor cu disfunctii sexuale.
2. Cariotipul realizat prin metode de bandare G ne ofera o privire de ansamblu asupra profilului genetic al individului studiat.
3. Utilizarea tehnicii FISH in laboratoarele de diagnostic citogenetic scurteaza timpul de raspuns si creste precizia analizei.
4. Un alt mare avantaj pe care l-am exploatat in lucrare este faptul ca se poate aplica si pe nuclei interfazici, nu doar pe preparate cromozomale- metafaze, cu rezultate precise- se poate pune un diagnostic in functie de sondele utilizate.
Avand acesta privire de ansamblu putem trece la studierea zonelor care sunt de interes prin intermediul tehnicii FISH. De aceea intr-un laborator citogenetic nu trebuie total abandonate tehnicile de bandare clasica in favoarea tehnicilor moleculare, ci trebuie realizata o combinatie intre cele doua in scopul unei analize cat mai acurate si competente.
1. PACIENT D.D.
DIAGNOSTIC : Sindrom Klinefelter
- PRODUS BIOLOGIC : Sange periferic din deget-frotiuri
- TIP DE ANALIZA :Test Barr

- REZULTAT : Frotiurile obtinute au fost colorate May-Grunwald-Giemsa. In urma examinarii microscopice se constata prezenta la nivelul polimorfonucletelor neutrofile a cromatinei sexuale.
- CONCLUZIE : Test Barr pozitiv
- PRODUS BIOLOGIC : Plasma
- TIP ANALIZA : Test ELIZA pentru determinarea nivelurilor plasmatice ale Testosteronului, FSH si LH plasmatic
- REZULTATE : Testosteronul = 1,5 NG/ML (valori normale barbati=2,4-12NG/ML)
FSH = 50 MUI/ML (valori normale barbati=2-10MUI/ML)
LH =50 MUI/ML (valori normale barbati=1-13,8MUI/ML)
2. PACIENT : M.M.
DIAGNOSTIC : Sindrom triplu X
PRODUS BIOLOGIC : sange periferic recoltat din deget- frotiuri
TIP DE ANALIZA :Test Barr

REZULTATE : In urma examinarii microscopice se constata prezenta la nivelul polimorfonucleatelor neutrofile a cromationei sexuale.
- PRODUS BIOLOGIC : Plasma
- TIP ANALIZA : Test ELIZA pentru determinarea nivelurilor plasmatice ale Testosteronului, FSH si Estradiolului plasmatic
- REZULTATE : Testosteronul = 0,32 NG/ML (valori normale femei= 0,1-1,2 NG/ML)
FSH = 18 MUI/ML (valori normale femei, ovulatie, ziua 14= 7-20)
Estradiol=270 PG/ML (valori normale femei, ovulatie, ziua 14= 130-370)
3. PACIENT : V.M.
DIAGNOSTIC : Sindrom Turner
PRODUS BIOLOGIC : sange periferic recoltat din deget- frotiuri
- TIP DE ANALIZA :Test Barr
- REZULTAT : Frotiurile obtinute au fost colorate May-Grunwald- Giemsa. In urma examinarii microscopice se constata absenta cromatinei sexuale.
- CONCLUZIE : Test Barr negativ
PRODUS BIOLOGIC : Sange periferic, recoltat pe heparina
TIP DE ANALIZA : Cariotip

- REZULTATE : S-au efectuat culturi de limfocite din sange periferic, sacrificate la 72 ore. Preparatele cromozomiale obtinute au fost colorate prin metoda de bandare G cu tripsin. In urma analizarii a 50 de metafaze se constata ca pacienta prezinta un cariotop 45,X0, caracteristic Sindromului Turner.
4. PACIENT : C. M. M.
DIAGNOSTIC : Sindrom Klinefelter
PRODUS BIOLOGIC : Sange periferic din deget- frotiuri
TIP DE ANALIZA : Test Barr
REZULTAT : Frotiurile obtinute au fost colorate May-Grunwald-Giemsa. In urma examinarii microscopice se constata prezenta la nivelul polimorfonucleatelor neutrofile, a cromatinei sexuale.
- CONCLUZIE : Test Barr pozitiv
PRODUS BIOLOGIC : Sange periferic recoltat pe heparina
TIP DE ANALIZA : Cariotip

REZULTAT : S-au efectuat culturi de limfocite din sange periferic, sacrificate la 72 ore. Pe preparatele cromozomiale obtinute s-a plicat metoda de bandare G cu tripsina. In urma examinarii a 50 de metafaze se constata ca pacientul prezinta cariotip 47,XXY, caracteristic Sindromului Klinefelter
- PRODUS BIOLOGIC : Plasma
- TIP ANALIZA : Test ELIZA pentru determinarea nivelurilor plasmatice ale Testosteronului, FSH si LH plasmatic
- REZULTATE : Testosteronul = 1,04 NG/ML (valori normale barbati=2,4-12NG/ML)
FSH = 47 MUI/ML (valori normale barbati=2-10MUI/ML)
LH =39 MUI/ML (valori normale barbati=1-13,8MUI/ML)
5. PACIENT : V.M.
DIAGNOSTIC : Sindrom Turner
PRODUS BIOLOGIC : Sange periferic recoltat pe heparina
TIP DE ANALIZA : FISH
![]()

- REZULTAT : Aplicarea tehnicii FISH pe nuclei interfazici a dus la evidentierea prezentei unui singur cromozom X.
BIBLIOGRAFIE
1. DIG Application Manual for Filter Hybridization Roche, Molecular Biochemicals, 2000
2. Genetica Medicala Progrese Recente. Dragos T. Stefanescu, George A. Calin, Fulvia C. Stefanescu, Editura Tehnica Bucuresti, 1998
3. Genetica- metode de laborator. P. Raicu, I. Anghel, Veronica Stoian, Doina Duma, Elena Taisescu, Elena Badea, Liliana Gregorian, Editura Academiei, 1983
4. Molecular Genetic Analysis of Populations. A Practical Approach Second edition A.R. Hoelzel IRL Press at Oxford University Press 1998
5.Molecular Cloning A Laboratory Manual Second edition J. Sambrook, E.F.Fritsch, T. Maniatis, Cold Spring Harbour Laboratory Press 1989
6. Human genetics. Problems and Approaches.Third edition. F. Vogel, A.G.Motulsky Springer 1997

Vizualizari: 3433
Importanta: ![]()
Termeni si conditii de utilizare | Contact
© SCRIGROUP 2025 . All rights reserved